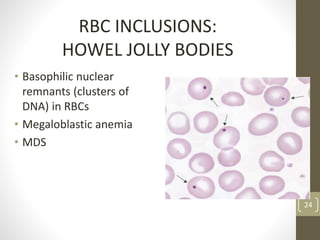
RBC INCLUSIONS:
HOWEL JOLLY BODIES
• Basophilic nuclear
remnants (clusters of
DNA) in RBCs
• Megaloblastic anemia
• MDS
24
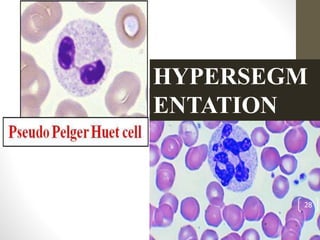
HYPERSEGM
ENTATION
28

This document provides an overview of pancytopenia, including definitions, common causes, clinical evaluation, and diagnostic approach. Pancytopenia is defined as a reduction in all three blood cell lines. The evaluation involves obtaining a complete blood count with peripheral smear, bone marrow aspiration and biopsy, and specific tests depending on findings. The bone marrow examination can help differentiate causes based on cellularity and features seen in erythropoiesis, myelopoiesis, megakaryopoiesis and other cell types. Common causes include bone marrow failure, infiltrative disorders, infections, immune disorders and nutritional deficiencies. A thorough history, examination and systematic evaluation of the bone marrow are required to identify the underlying cause of pancy